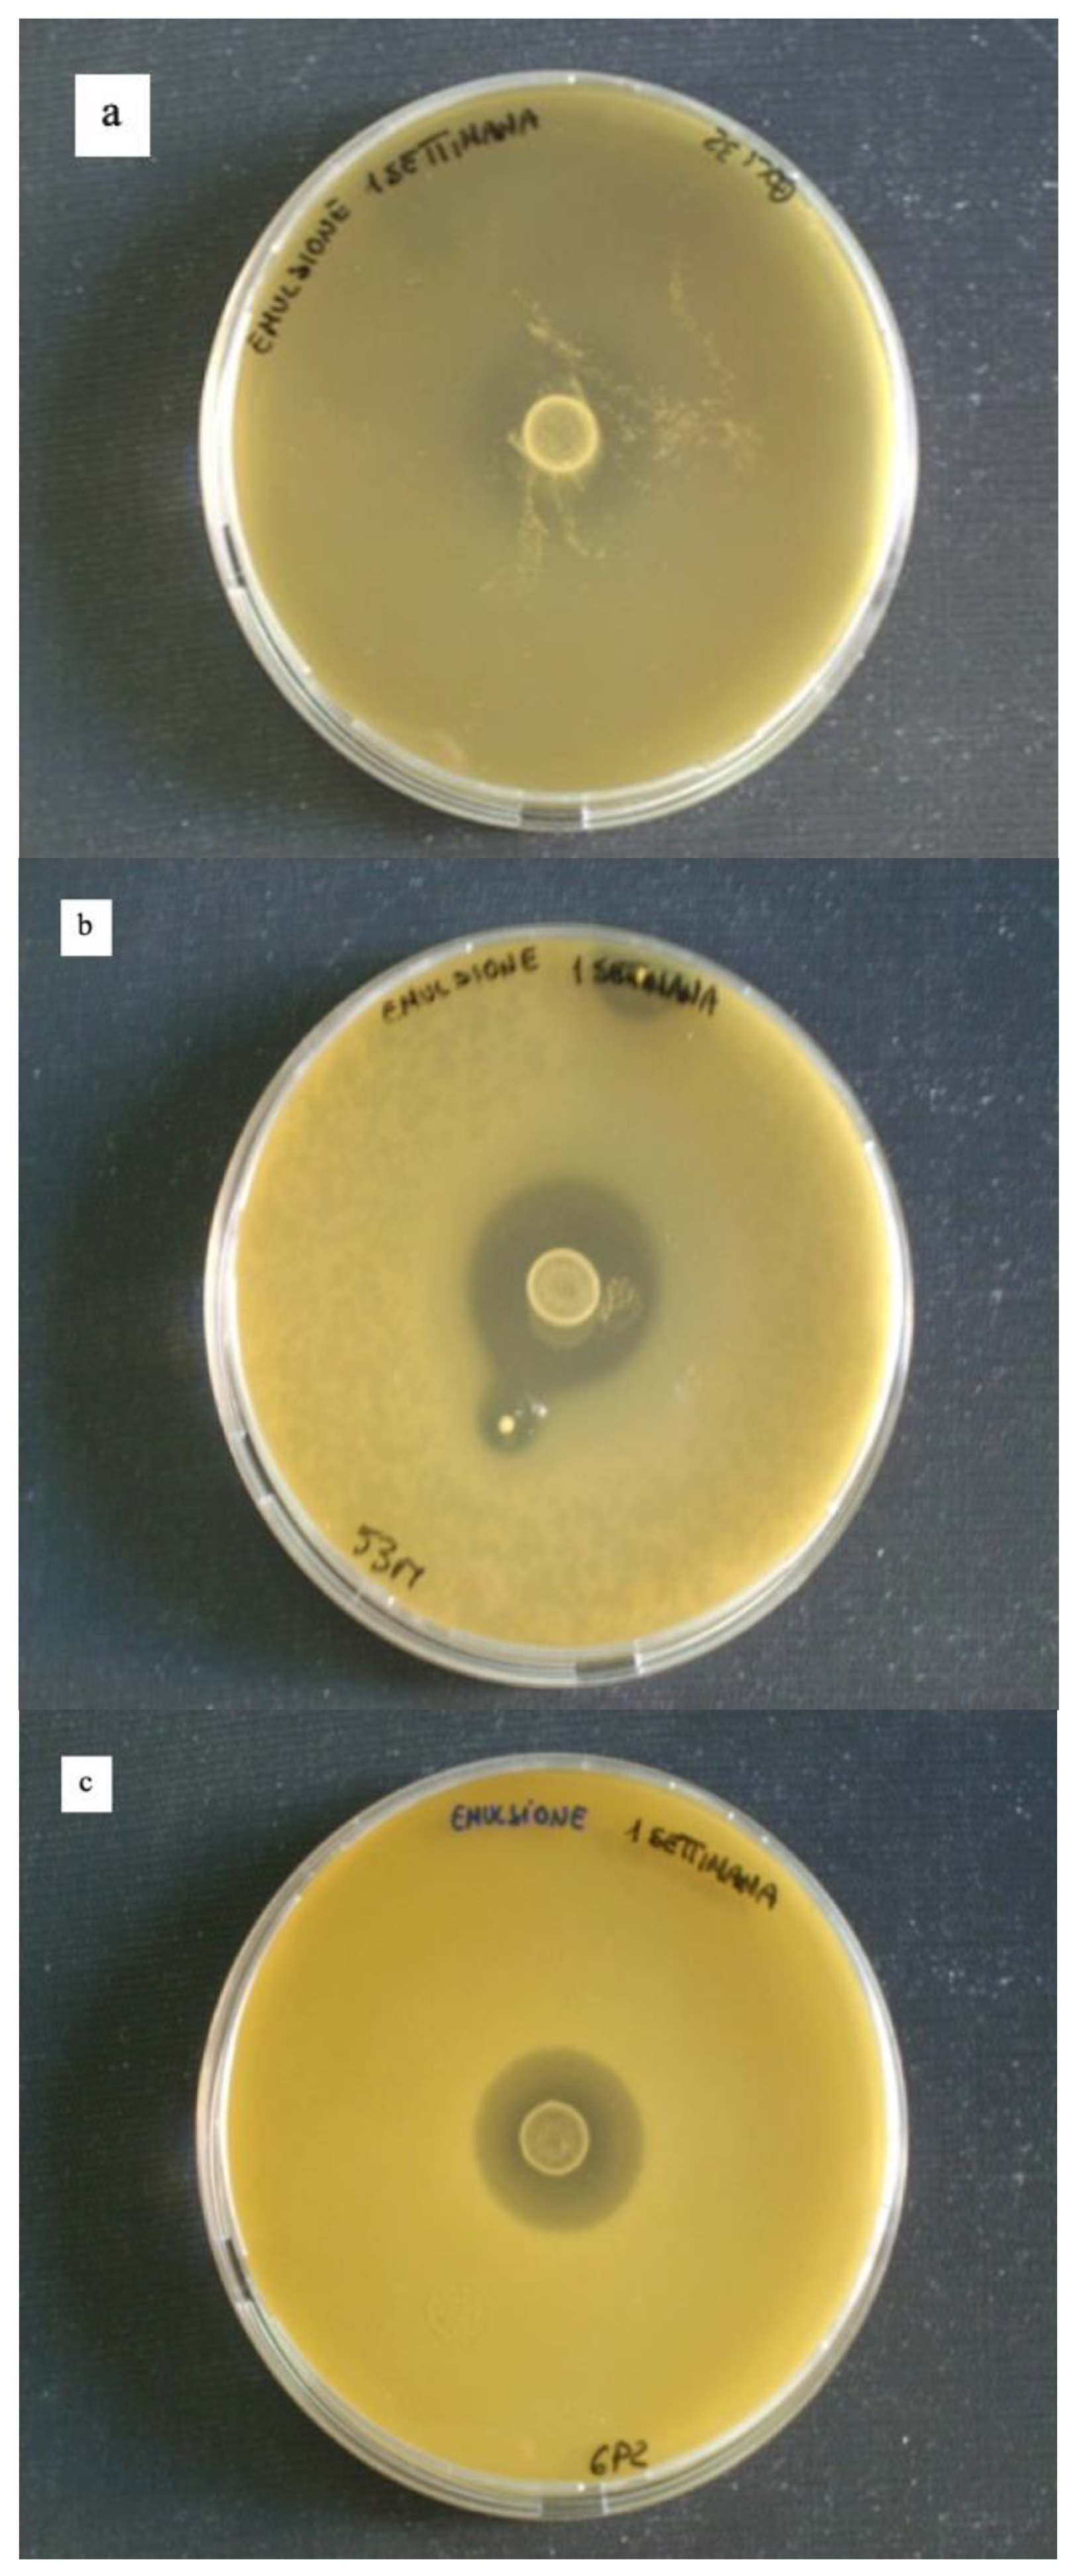

Effect of Microencapsulation on Survival at Simulated Gastrointestinal Conditions and Heat Treatment of a Non Probiotic Strain, Lactiplantibacillus plantarum 48M, and the Probiotic Strain Limosilactobacillus reuteri DSM 17938
Abstract
1. Introduction
2. Materials and Methods
2.1. Microorganisms and Culture Conditions
2.2. Microorganisms Microencapsulation
2.3. Enumeration of Microencapsulated Cells
2.4. Calculation of Microencapsulation Efficiency
2.5. Simulated GI Conditions
2.6. Heat Treatments
2.7. Viable Staining of Microencapsulated Bacterial Cells
2.8. Reuterin Production Assay
2.9. Data Analysis
3. Results and Discussion
3.1. Microencapsulation and Encapsulation Efficiency
3.2. Simulated GI Conditions
3.3. Heat Treatment of Free and Microencapsulated Cells
3.4. Reuterin Production Assay
4. Conclusions
Author Contributions
Funding
Data Availability Statement
Conflicts of Interest
References
- Korhonen, H. Technology options for new nutritional concepts. Int. J. Dairy Technol. 2002, 55, 79–88. [Google Scholar] [CrossRef]
- Vasiljevic, T.; Shah, N.P. Probiotics-from Metchnikoff to bioactives. Int. Dairy J. 2008, 18, 714–728. [Google Scholar] [CrossRef]
- Wiseman, A.; Woods, L. Addition of designer enhancers to functional foods: Need also for redesigned biocatalysts in fail-clean strategies of bioprocessing? J. Chem. Technol. Biol. 2001, 76, 1038–1040. [Google Scholar] [CrossRef]
- Tur, J.A.; Bibiloni, M.M. Functional foods. Reference module in food science. In Encyclopedia of Food and Health; Elsevier: Kidlington, UK, 2016. [Google Scholar]
- Heller, K.J. Probiotic bacteria in fermented foods: Product characteristics and starter organisms. Am. J. Clin. Nutr. 2001, 72, 374S–379S. [Google Scholar] [CrossRef] [PubMed]
- Stanton, C.; Gardiner, G.; Meehan, H.; Collins, K.; Fitzgerald, G.; Lynch, P.B.; Ross, R.P. Market potential for probiotics. Am. J. Clin. Nutr. 2001, 73, 476S–483S. [Google Scholar] [CrossRef]
- Hill, C.; Guarner, F.; Reid, G.; Gibson, G.R.; Merenstein, D.J.; Pot, B.; Morelli, L.; Canani, R.B.; Flint, H.J.; Salminen, S.; et al. The International Scientific Association for Probiotics and Prebiotics consensus statement on the scope and appropriate use of the term probiotic. Nat. Rev. Gastroenterol. Hepatol. 2014, 11, 506–514. [Google Scholar] [CrossRef]
- FAO/WHO. Report of a Joint FAO/WHO Expert Consultation on Evaluation of Health and Nutritional Properties of Probiotics in Food Including Powder Milk With Live Lactic Acid Bacteria; FAO: Rome, Italy, 2001. [Google Scholar]
- Zheng, J.; Wittouck, S.; Salvetti, E.; Franz, C.M.A.P.; Harris, H.M.B.; Mattarelli, P.; O’Toole, P.W.; Pot, B.; Vandamme, P.; Walter, J.; et al. A taxonomic note on the genus Lactobacillus: Description of 23 novel genera, emended description of the genus Lactobacillus Beijerinck 1901, and union of Lactobacillaceae and Leuconostocaceae. Int. J. Syst. Evol. Microbiol. 2020, 70, 2782–2858. [Google Scholar] [CrossRef]
- Figueroa-Gonzales, I.; Quijano, G.; Ramirez, G.; Cruz-Guerrero, A. Probiotics and prebiotics- perspectives and challenges. J. Sci. Food Agric. 2011, 91, 1341–1348. [Google Scholar] [CrossRef]
- Tripathi, M.K.; Giri, S.K. Probiotic functional foods: Survival of probiotics during processing and storage. J. Funct. Foods 2014, 9, 225–241. [Google Scholar] [CrossRef]
- Yao, M.; Xie, J.; Du, H.; McClements, D.J.; Xiao, H.; Li, L. Progress in microencapsulation of probiotics: A review. Compr. Rev. Food Sci. Food Saf. 2020, 19, 857–874. [Google Scholar] [CrossRef]
- Anal, A.K.; Stevens, W.F. Chitosan-alginate multilayer beads for controlled release of ampicillin. Int. J. Pharm. 2005, 290, 45–54. [Google Scholar] [CrossRef] [PubMed]
- Anal, A.K.; Singh, H. Recent advances in microencapsulation of probiotics for industrial applications and targeted delivery. Trends Food Sci. Techol. 2007, 18, 240–251. [Google Scholar] [CrossRef]
- De Vos, P.; Faas, M.M.; Spasojevic, M.; Sikkema, J. Encapsulation for preservation of functionality and targeted delivery of bioactive food components. Int. Dairy J. 2010, 20, 292–302. [Google Scholar] [CrossRef]
- Song, H.; Yu, W.; Gao, M.; Liu, X.; Ma, X. Microencapsulated probiotics using emulsification technique coupledwith internal or external gelation process. Carbohydr. Polym. 2013, 96, 181–189. [Google Scholar] [CrossRef] [PubMed]
- Krasaekoopt, W.; Bhandari, B.; Deeth, H. Evaluation of encapsulation techniques of probiotics for yoghurt. Int. Dairy J. 2003, 13, 3–13. [Google Scholar] [CrossRef]
- Mu, Q.; Tavella, V.J.; Luo, X.M. Role of Lactobacillus reuteri in human health and diseases. Front. Microbiol. 2018, 9, 757. [Google Scholar] [CrossRef]
- Cleusix, V.; Lacroix, C.; Vollenweider, S.; Le Blay, G. Glycerol induces reuterin production and decreases Escherichia coli population in an in vitro model of colonic fermentation with immobilized human feces. FEMS Microbiol. Ecol. 2008, 63, 56–64. [Google Scholar] [CrossRef]
- Talarico, T.L.; Casas, I.A.; Chung, T.C.; Dobrogosz, W.J. Production and isolation of reuterin: A growth inhibitor produced by Lactobacillus reuteri. Antimicrob. Agents Chemother. 1988, 32, 1854–1858. [Google Scholar] [CrossRef]
- Liu, Y.W.; Liong, M.T.; Tsai, Y.C. New perspectives of Lactobacillus plantarum as a probiotic: The gut-heart-brain axis. J. Microbiol. 2018, 56, 601–613. [Google Scholar] [CrossRef]
- Ercolini, D.; Russo, F.; Nasi, A.; Ferranti, P.; Villani, F. Mesophilic and psychotropic bacteria from meat and their spoilage potential in vitro and in beef. Appl. Environ. Microb. 2009, 75, 1990–2001. [Google Scholar] [CrossRef]
- Sheu, T.Y.; Mashall, R.T. Microentrapment of lactobacilli in calcium alginate gels. J. Food Sci. 1993, 54, 557–561. [Google Scholar] [CrossRef]
- Truelstrup Hansen, L.; Allan-Wojtas, P.M.; Jin, Y.L.; Paulson, A.T. Survival of Ca-alginate microencapsulated Bifidobacterium spp. in milk and simulated gastrointestinal conditions. Food Microbiol. 2002, 19, 35–45. [Google Scholar] [CrossRef]
- Malmo, C.; La Storia, A.; Mauriello, G. Microencapsulation of Lactobacillus reuteri DSM 17938 cells coated in alginate beads with chitosan by spray drying to use as a probiotic cell in a chocolate soufflé. Food Bioprocess. Technol. 2013, 6, 795–805. [Google Scholar] [CrossRef]
- Villani, F.; Salzano, G.; Sorrentino, E.; Pepe, O.; Marino, P.; Coppola, S. Enterocin 226 NWC, a bacteriocin produced by Enterococcus faecalis 226 active against Listeria monocytogenes. J. Appl. Bacteriol. 1993, 74, 380–387. [Google Scholar] [CrossRef] [PubMed]
- Sultana, K.; Godward, G.; Reynolds, N.; Arumugaswamy, R.; Peiris, P.; Kailasapathy, K. Encapsulation of probiotic bacteria with alginate–starch and evaluation of survival in simulated gastrointestinal conditions and in yoghurt. Int. J. Food Microbiol. 2000, 62, 47–55. [Google Scholar] [CrossRef]
- Valero-Cases, E.; Frutos, M.J. Effect of different types of encapsulation on the survival of Lactobacillus plantarum during storage with inulin and in vitro digestion. LWT Food Sci. Technol. 2014, 64, 824–828. [Google Scholar] [CrossRef]
- Kandemir, N.; Vollmer, W.; Jakubovics, N.S.; Chen, J. Mechanical interactions between bacteria and hydrogels. Sci. Rep. 2018, 8, 10893. [Google Scholar] [CrossRef]
- De Prisco, A.; Maresca, D.; Ongeng, D.; Mauriello, G. Microencapsulation by vibrating technology of the probiotic strain Lactobaciluus reuteri DSM 17938 to enhance its survival in foods and in gastrointestinal environment. LWT Food Sci. Technol. 2015, 61, 452–462. [Google Scholar] [CrossRef]
- De Prisco, A.; von Valenberg, H.J.F.; Fogliano, V.; Mauriello, G. Microencapsulated starter culture during yoghurt manufacturing, effect on technological features. Food. Bioprocess. Technol. 2017, 10, 1767–1777. [Google Scholar] [CrossRef]
- Iyer, C.; Kailasapathy, K. Effect of co-encapsulation of probiotics with prebiotics on increasing the viability of encapsulated bacteria under in vitro acidic and bile salt conditions and in yogurt. J. Food Sci. 2005, 70, 18–23. [Google Scholar]
- Lee, K.Y.; Heo, T.R. Survival of Bifidobacterium longum immobilized in calcium alginate beads in simulated gastric juices and bile salt solution. Appl. Environ. Microbiol. 2000, 66, 869–873. [Google Scholar] [CrossRef] [PubMed]
- Mandal, S.; Puniya, A.K.; Singh, K. Effect of alginate concentrations on survival of microencapsulated Lactobacillus casei NCDC-298. Int. Dairy J. 2006, 16, 1190–1195. [Google Scholar] [CrossRef]
- Sathyabama, S.; Ranjith, K.M.; Devi, P.B.; Vijayabharathi, R.; Priyadharisini, V.B. Co-encapsulation of probiotics with prebiotics on alginate matrix and its effect on viability in simulated gastric environment. Food Sci. Technol. 2014, 57, 419–425. [Google Scholar] [CrossRef]
- Muthukumarasamy, P.; Allan-Wojtas, P.; Holley, R.A. Stability of Lactobacillus reuteri in different type of microcapsules. J. Food Sci. 2006, 71, 20–24. [Google Scholar] [CrossRef]
- Smidsrod, O.; Skijak-Brack, G. Alginate as immobilization matrix for cells. Trends Biotechnol. 1990, 8, 71–78. [Google Scholar] [CrossRef]
- Gasol, J.M.; Zweifel, U.L.; Peters, F.; Fuhrman, J.A.; Hagstrom, A. Significance of size and nucleic acid content heterogeneity as measured by flow cytometry in natural planktonic bacteria. Appl. Environ. Microbiol. 1999, 65, 4475–4483. [Google Scholar] [CrossRef]
- Sachidanandham, R.; Gin, K.Y.; Poh, C.L. Monitoring of active but non-culturable bacterial cells by flow cytometry. Biotechnol. Bioeng. 2005, 89, 24–31. [Google Scholar] [CrossRef]
- Berney, M.; Weilenmann, H.U.; Egli, T. Flow-cytometric study of vital cellular functions in Escherichia coli during solar disinfection (SODIS). Microbiology 2006, 152, 1719–1729. [Google Scholar] [CrossRef]
- Nebe-von-Caron, G.; Stephens, P.J.; Hewitt, C.J.; Powell, J.R.; Badley, R.A. Analysis of bacterial function by multi-colour fluorescence flow cytometry and single cell sorting. J. Microbiol. Meth. 2000, 42, 97–114. [Google Scholar] [CrossRef]
- Joux, F.; Lebaron, P. Use of fluorescent probes to assess physiological functions of bacteria at single-cell level. Microbes Infect. 2000, 2, 1523–1535. [Google Scholar] [CrossRef]
- Barbesti, S.; Citterio, S.; Labra, M.; Baroni, M.D.; Neri, M.G.; Sgorbati, S. Two- and three-color fluorescence flow cytometric analysis of immunoidentified viable bacteria. Cytometry 2000, 40, 214–218. [Google Scholar] [CrossRef]
- Christiansen, T.; Michaelsen, S.; Wumpelmann, M.; Nielsen, J. Production of savinase and population viability of Bacillus clausii during high-cell-density fed-batch cultivations. Biotechnol. Bioeng. 2003, 83, 344–352. [Google Scholar] [CrossRef] [PubMed]
- Hoefel, D.; Grooby, W.L.; Monis, P.T.; Andrews, S.; Saint, C.P. Enumeration of water-borne bacteria using viability assays and flow cytometry: A comparison to culture-based techniques. J. Microbiol. Meth. 2003, 55, 585–597. [Google Scholar] [CrossRef]
- Virta, M.; Lineri, S.; Kankaanpaa, P.; Karp, M.; Peltonen, K.; Nuutila, J.; Lilius, E.M. Determination of complement-mediated killing of bacteria by viability staining and bioluminescence. Appl. Environ. Microbiol. 1998, 64, 515–519. [Google Scholar] [CrossRef]
- Ding, W.K.; Shah, N.P. Acid, bile, and heat tolerance of free and microencapsulated probiotic bacteria. J. Food Sci. 2007, 72, M446–M450. [Google Scholar] [CrossRef]

| Phases | Volume of Each Phase mL | L. reuteri DSM 17938 | L. plantarum 48M | ||||
|---|---|---|---|---|---|---|---|
| Fluorescence Microscopy | Log CFU/mL | Encapsulation Efficiency % | Fluorescence Microscopy | Log CFU/mL | Encapsulation Efficiency % | ||
| OILY | 160 | No free cells, no microcapsules | 0 | No free cells, no microcapsules | 0 | ||
| WATER | 20 | Free Cells | 7.36 | Free Cells | 4.47 | ||
| CAPSULES | 30 | Microcapsules with some free cells | 9.04 | 91.53 | Microcapsules with some free cells | 7.63 | 65.28 |
| Sample | L. reuteri DSM 17938 | L. plantarum 48M | ||||||
|---|---|---|---|---|---|---|---|---|
| 60 °C × 3′ | 70 °C × 2′ | 80 °C × 2′ | 80 °C × 5′ | 60 °C × 3′ | 70 °C × 2′ | 80 °C × 2′ | 80 °C × 5′ | |
| free cells | 1.02 | 4.2 × 10−3 | 0.0011 | 1.9 × 10−6 | 0.0039 | 3.5 × 10−4 | 7.8 × 10−5 | 3.0 × 10−5 |
| microencapsulated cells | 0.89 | 2.1 × 10−3 | 4.2 × 10−3 | 1.3 × 10−6 | 8.0 × 10−5 | 0.0 | 0.0 | 0.0 |
Publisher’s Note: MDPI stays neutral with regard to jurisdictional claims in published maps and institutional affiliations. |
© 2021 by the authors. Licensee MDPI, Basel, Switzerland. This article is an open access article distributed under the terms and conditions of the Creative Commons Attribution (CC BY) license (http://creativecommons.org/licenses/by/4.0/).
Share and Cite
Malmo, C.; Giordano, I.; Mauriello, G. Effect of Microencapsulation on Survival at Simulated Gastrointestinal Conditions and Heat Treatment of a Non Probiotic Strain, Lactiplantibacillus plantarum 48M, and the Probiotic Strain Limosilactobacillus reuteri DSM 17938. Foods 2021, 10, 217. https://doi.org/10.3390/foods10020217
Malmo C, Giordano I, Mauriello G. Effect of Microencapsulation on Survival at Simulated Gastrointestinal Conditions and Heat Treatment of a Non Probiotic Strain, Lactiplantibacillus plantarum 48M, and the Probiotic Strain Limosilactobacillus reuteri DSM 17938. Foods. 2021; 10(2):217. https://doi.org/10.3390/foods10020217
Chicago/Turabian StyleMalmo, Clorinda, Irene Giordano, and Gianluigi Mauriello. 2021. "Effect of Microencapsulation on Survival at Simulated Gastrointestinal Conditions and Heat Treatment of a Non Probiotic Strain, Lactiplantibacillus plantarum 48M, and the Probiotic Strain Limosilactobacillus reuteri DSM 17938" Foods 10, no. 2: 217. https://doi.org/10.3390/foods10020217
APA StyleMalmo, C., Giordano, I., & Mauriello, G. (2021). Effect of Microencapsulation on Survival at Simulated Gastrointestinal Conditions and Heat Treatment of a Non Probiotic Strain, Lactiplantibacillus plantarum 48M, and the Probiotic Strain Limosilactobacillus reuteri DSM 17938. Foods, 10(2), 217. https://doi.org/10.3390/foods10020217

